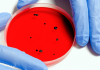
Monitoramento de vírus, fungos e bactérias poderá evitar novas pandemias

Recurso é, por enquanto, exclusivo para usuários paulistanos.
O aplicativo de mensagens WhatsApp anunciou que a cidade de São Paulo foi escolhida para testar uma nova funcionalidade que permite localizar bares, restaurantes, lanchonetes e outros tipos de empreendimento que usam a plataforma para fazer negócios.
A novidade, que será testada exclusivamente no Brasil, será chamada Guia de Negócios e funcionará como uma espécie de mapa de locais recomendados por usuários.
“No momento, o guia está disponível somente para algumas empresas no centro da cidade de São Paulo que vendem produtos e serviços na região, incluindo alimentação, varejo e educação. Com o tempo, esperamos incluir mais categorias e áreas geográficas, e disponibilizar o guia para mais para empresas que usam o app”, informou a empresa em comunicado.
Para as empresas que tiverem interesse em aderir e estejam localizadas no centro da cidade de São Paulo, o WhatsApp disponibilizou um vídeo explicativo para o processo de cadastro.
Assista:
Para usuários, a opção estará disponível em uma aba exclusiva que aparecerá com a atualização do aplicativo. Como é focada no mercado paulista, indicações de negócios ainda não aparecerão para os públicos de outras localidades.
Segundo pesquisa da empresa especializada em mercados de aplicativos e internet Statista, o WhatsApp conta com um mercado global de 2 bilhões de usuários, dos quais 120 milhões são brasileiros. O país fica atrás apenas da Índia, que tem 400 milhões de linhas móveis cadastradas no WhatsApp.
*Informações/AgênciaBrasil